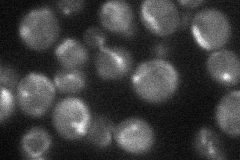
YAL010C
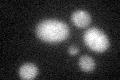
YAL010C

View description
Subunit of both the ERMES complex that links the ER to mitochondria, and of the mitochondrial sorting and assembly machinery (SAM complex) that functions in import and assembly of outer membrane beta-barrel proteins
Localization:
Intensity:
Fold change:
Significance:
-
C’ GFP library in SD

below threshold14.72 -
N' NOP1pr-GFP in SD
mitochondria25.5189 -
N' TEF2pr-mCherry in SD

mitochondria10.0216 -
N' NATIVEpr-GFP in SD

mitochondria20.6236 -
N' TEF2pr-VC and Cyto-VN in SD

below threshold25.5889 -
C’ GFP library in SD+DTT
cytosol14.530.98No -
C’ GFP library in SD+H2O2

cytosol14.751No -
C’ GFP library in Starvation Media

cytosol16.581.12No -
C’ GFP library on the background of Pup2-DaMP

below threshold -
C’ GFP library on the background of CCT mutant

below threshold15.48361.05117No
